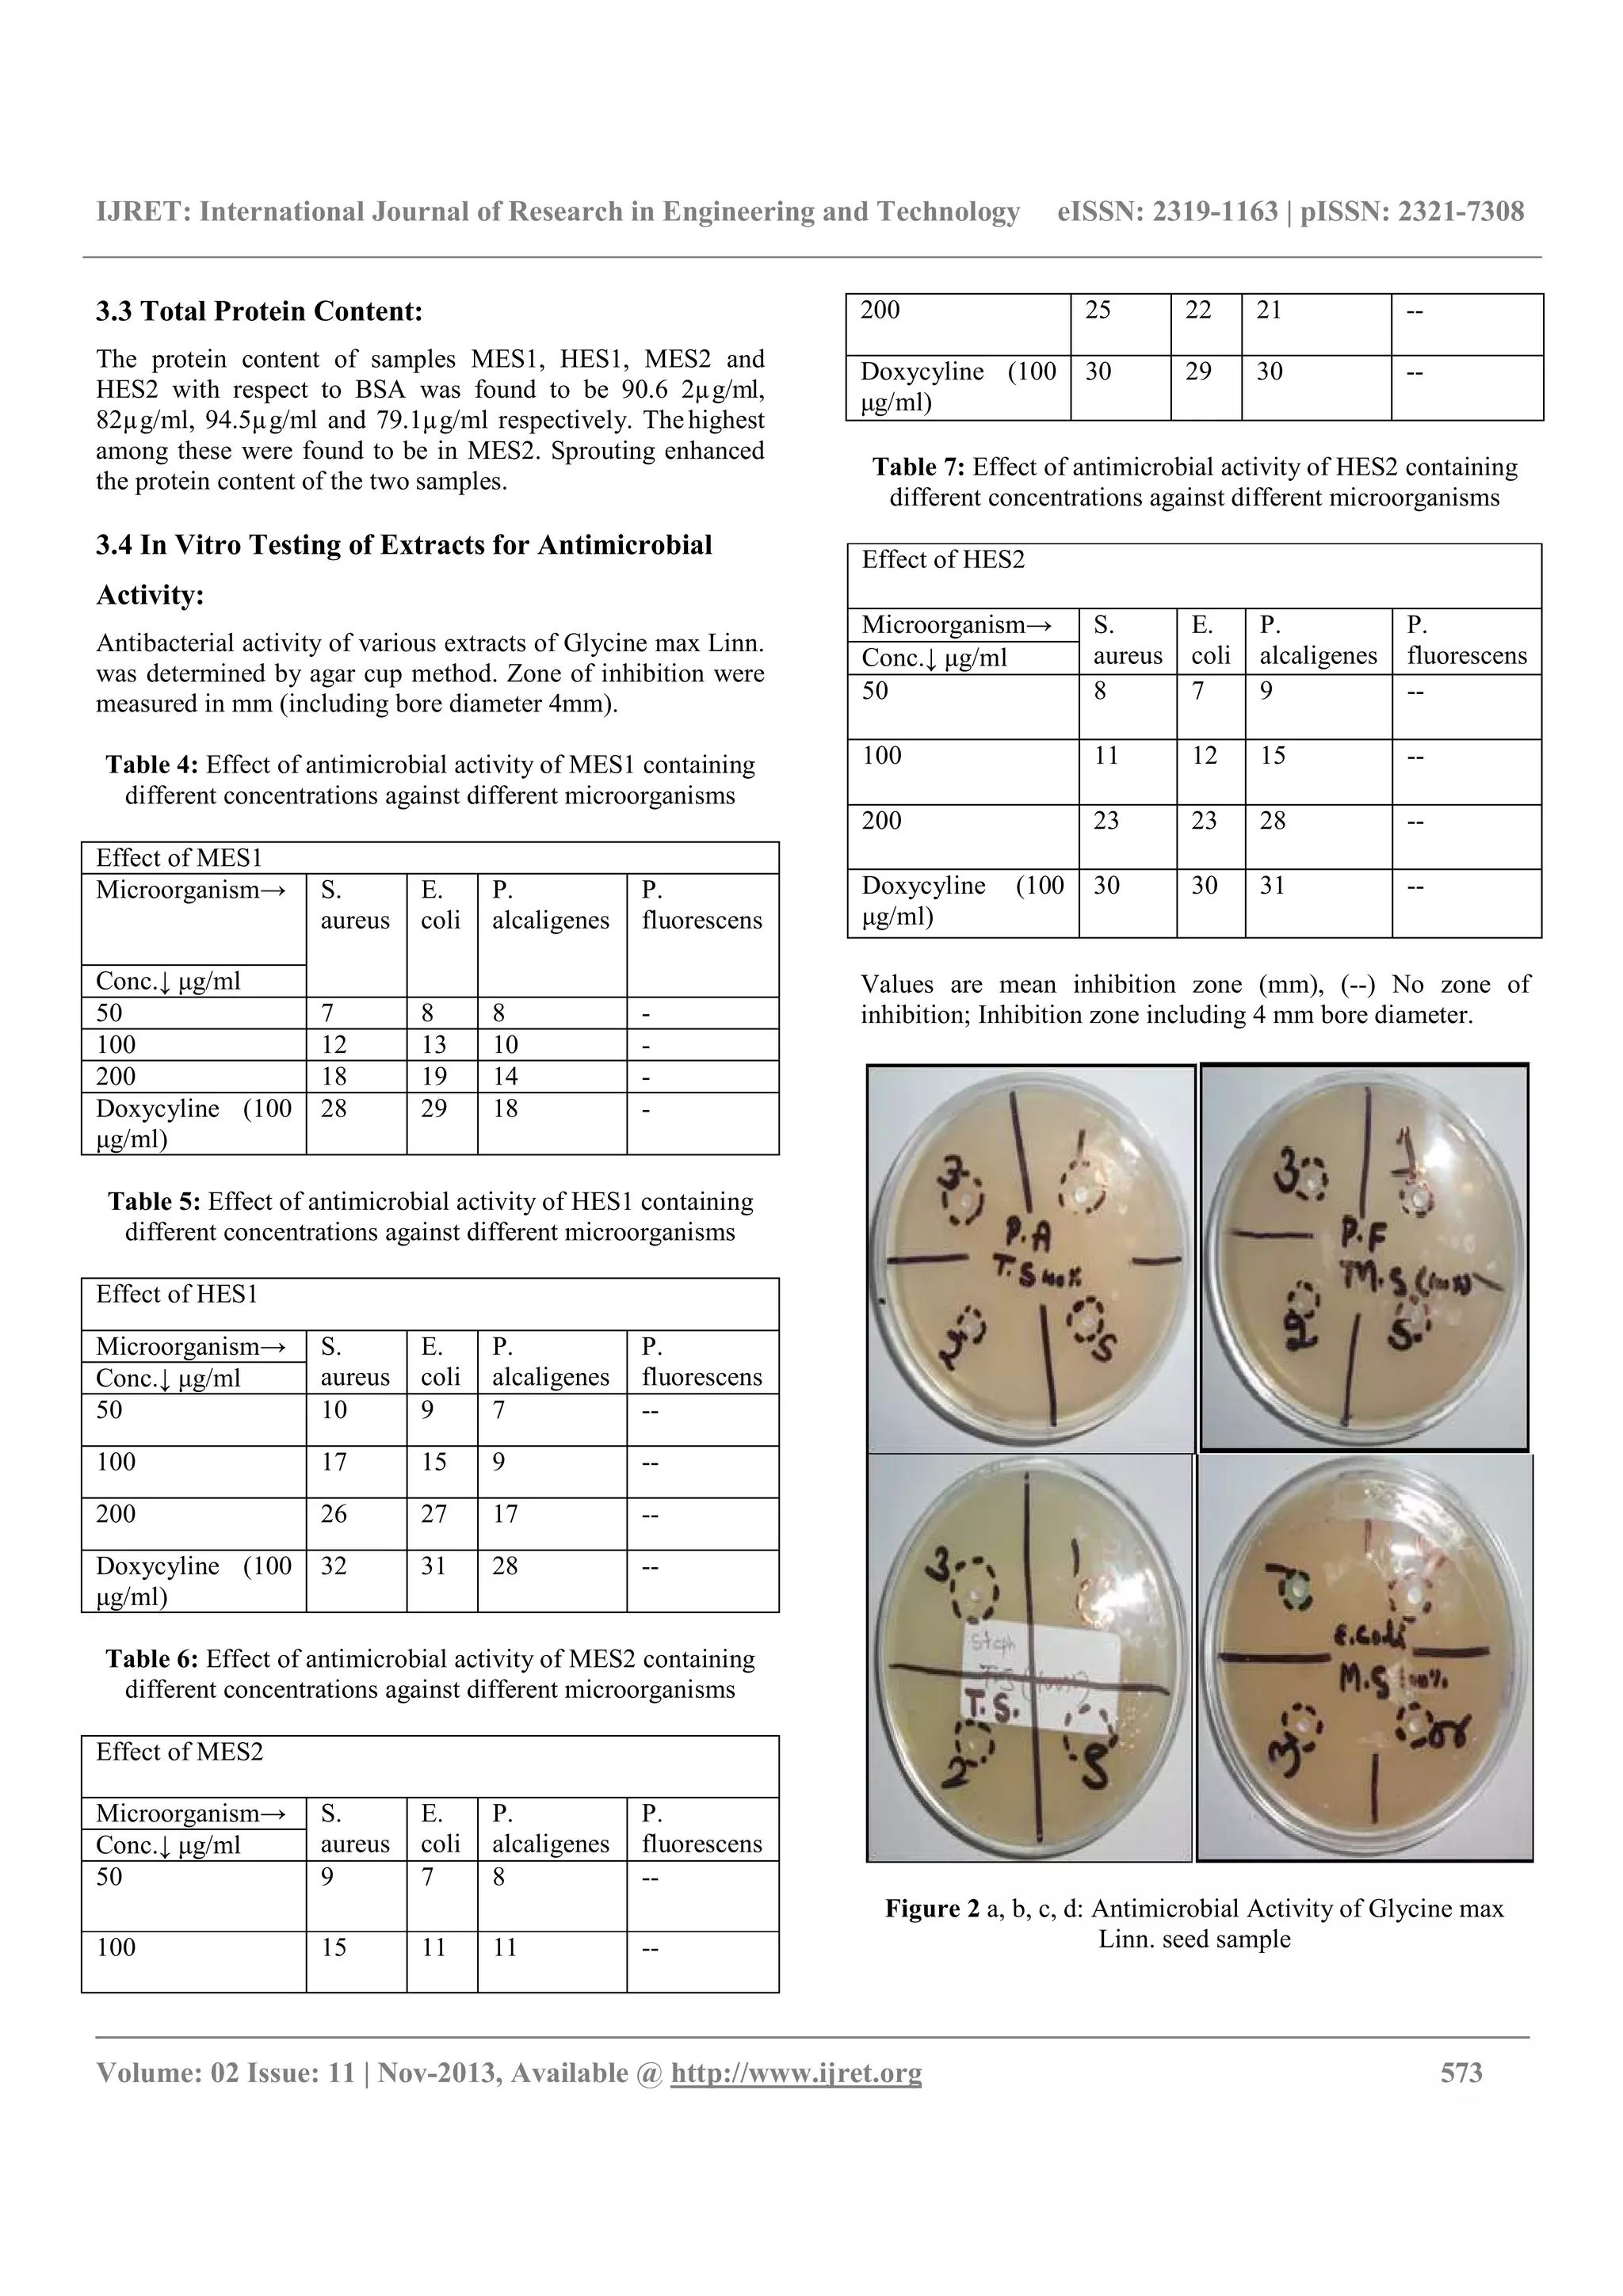
IJRET: International Journal of Research in Engineering and Technology eISSN: 2319-1163 | pISSN: 2321-7308
__________________________________________________________________________________________
Volume: 02 Issue: 11 | Nov-2013, Available @ http://www.ijret.org 573
3.3 Total Protein Content:
The protein content of samples MES1, HES1, MES2 and
HES2 with respect to BSA was found to be 90.6 2µg/ml,
82µg/ml, 94.5µg/ml and 79.1µg/ml respectively. The highest
among these were found to be in MES2. Sprouting enhanced
the protein content of the two samples.
3.4 In Vitro Testing of Extracts for Antimicrobial
Activity:
Antibacterial activity of various extracts of Glycine max Linn.
was determined by agar cup method. Zone of inhibition were
measured in mm (including bore diameter 4mm).
Table 4: Effect of antimicrobial activity of MES1 containing
different concentrations against different microorganisms
Effect of MES1
Microorganism→ S.
aureus
E.
coli
P.
alcaligenes
P.
fluorescens
Conc.↓ μg/ml
50 7 8 8 -
100 12 13 10 -
200 18 19 14 -
Doxycyline (100
μg/ml)
28 29 18 -
Table 5: Effect of antimicrobial activity of HES1 containing
different concentrations against different microorganisms
Effect of HES1
Microorganism→ S.
aureus
E.
coli
P.
alcaligenes
P.
fluorescensConc.↓ μg/ml
50 10 9 7 --
100 17 15 9 --
200 26 27 17 --
Doxycyline (100
μg/ml)
32 31 28 --
Table 6: Effect of antimicrobial activity of MES2 containing
different concentrations against different microorganisms
Effect of MES2
Microorganism→ S.
aureus
E.
coli
P.
alcaligenes
P.
fluorescensConc.↓ μg/ml
50 9 7 8 --
100 15 11 11 --
200 25 22 21 --
Doxycyline (100
μg/ml)
30 29 30 --
Table 7: Effect of antimicrobial activity of HES2 containing
different concentrations against different microorganisms
Effect of HES2
Microorganism→ S.
aureus
E.
coli
P.
alcaligenes
P.
fluorescensConc.↓ μg/ml
50 8 7 9 --
100 11 12 15 --
200 23 23 28 --
Doxycyline (100
μg/ml)
30 30 31 --
Values are mean inhibition zone (mm), (--) No zone of
inhibition; Inhibition zone including 4 mm bore diameter.
Figure 2 a, b, c, d: Antimicrobial Activity of Glycine max
Linn. seed sample

The document summarizes a study that analyzed two samples of Glycine max Linn (soybean) seeds. Phytochemical analysis found various constituents including proteins, flavonoids, and phenolic compounds. Protein content was highest in the methanolic extract of sample 2. Thin layer chromatography identified several compounds in the extracts. Extracts showed antimicrobial activity against gram-positive and gram-negative bacteria, with the highest activity in the methanolic extract of sprouted sample 1.

![IJRET: International Journal of Research in Engineering and Technology eISSN: 2319-1163 | pISSN: 2321-7308
__________________________________________________________________________________________
Volume: 02 Issue: 11 | Nov-2013, Available @ http://www.ijret.org 574
CONCLUSIONS
Phytochemical analysis indicated the presence of various
phytoconstituentsviz.phytosterols, flavonoids, phenolic
compounds, tannins, carbohydrates, proteins, amino acids,
fixed oils and fats etc. Thin layer chromatography study on
extracts revealed the presence of a number of compounds. The
protein content of samples MES1, HES1, MES2 and HES2
with respect to BSA was found to be 90.6 2µg/ml, 82µg/ml,
94.5µg/ml and 79.1µg/ml respectively. The highest among
these were found to be in MES2. Sprouting enhanced the
protein content of the two samples.
There was significant enhancement of antibacterial activity of
all extracts with increasing concentration for selected
microbial strains. At higher concentration i.e. 200 μg/ml the
results were comparable with the standard Doxycycline. The
study showed that HES1 show more potent activity against
Staphylococcus aureus and Escherichia coli, where as HES2
show more potent activity against Pseudomonas alcaligenes
among others extracts.
REFERENCES
[1] MingmaR., Pathom-aree W., Trakulnaleamsai
S., Thamchaipenet A., Duangmal K., Isolation of
rhizospheric and roots endophytic actinomycetes
from Leguminosae plant and their activities to
inhibit soybean pathogen, Xanthomonas
campestris pv. Glycine. World Journal of
Microbiology and Biotechnology August 2013.
[2] Ponnusha B.S., Subramaniyam S., Pasupathi P.,
Subramaniyam B., Virumandy R., studied the
antioxidant and antimicrobial properties of Glycine
max. Int J Cur Bio Med Sci. 2011, (2): 49 – 62.
[3] Chaturvedi S., Hemamalini R. and Khare S.K., Effect
of processing conditions on saponin content and
antioxidant activity of Indian varieties of soybean
(Glycine max Linn.), Annals of Phytomedicine. 2012,
1(1): 62-68.
[4] Rao A.S., Reddy S.G., Babu P.P. and Reddy A.R., The
antioxidant and antiproliferative activities of
methanolic extracts from Njavara rice bran. BMC
Complement Altern Med. 2010, 10(4):1-9.
[5] Harborne, J.B.,(1998). Phytochemical Methods.
Chapman and Hall, London, 3rd
Edn. Pp:1-254.
[6] Egon and Stahl.,(2005). Thin layer chromatography: A
laboratory handbook. Springer Indiaprivate Limited. 52
pp:105
[7] Indian Pharmacopoeia (1996). Volume 1 (A-O).
[8] James, O., Chukwuemeka, S.E., Eyenetu, H.E., (2010).
Antibacterial and antioxidant activity of Saba florida
(Benth) extracts. Bioscience Tech. 1(4): 180-186.
[9] Soni A. and Sosa S., Phytochemical Analysis and Free
Radical Scavenging Potential of Herbal and Medicinal
Plant Extracts. Journal of Pharmacognosy and
Phytochemistry 2013; 2 (4): 22-29
[10] Doss A. and Anand. S.P., Preliminary Phytochemical
Screening of Asteracantha longifolia and Pergularia
daemia. World Applied Sciences Journal 18 (2): 233-
235, 2012.
BIOGRAPHIES:
The author is Associate Professor in
Biotechnology at A.S.B.A.S.J.S.M. College
Bela Roopnagar. She is coordinator of
Internal Quality Assurance Cell of the P.G.
College as well as U.G.C. She has done
B.Sc., B.Ed. and M.Ed. from Punjab
University Chandigarh. M.Sc. from Punjabi
University Patiala. She has qualified CSIR NET in Life
Science and U.G.C. NET in Education. She has worked for
four years in Pharmacy College, Bela and presently working
as HOD Biotechnology, PG College Bela. She has got best
teacher and best coordinator award 2013 .She has designed
syllabus for add on courses and was member of board of
study Biotechnology Punjabi University Patiala. She has
presented various national and International papers. She has
organised various Faculty Development Programmes and Co
The author has completed B.Pharm and
M.Pharm. from Panjab University,
Chandigarh. He has guided 37 students for
projects of B.Pharm, M.Pharm and
Biotechnology. He has published various
national and International papers. He is
member of APTE, Regd. Pharmacist with
Pharmacy Council of Punjab. He has qualified GATE and
submitted Ph.D. thesis.](https://image.slidesharecdn.com/phytochemicalanalysisproteincontent-140807010754-phpapp02/75/Phytochemical-analysis-protein-content-5-2048.jpg)